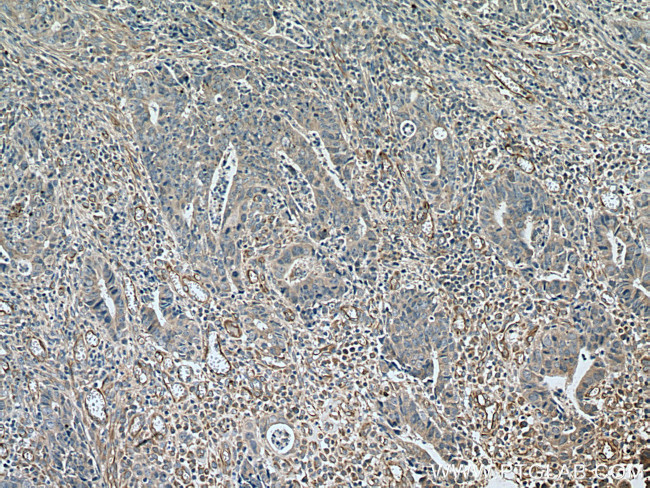
TYRO3 Antibody in Immunohistochemistry (Paraffin) (IHC (P))

Search
Proteintech
TYRO3 Polyclonal Antibody
{{$productOrderCtrl.translations['antibody.pdp.commerceCard.promotion.promotions']}}
{{$productOrderCtrl.translations['antibody.pdp.commerceCard.promotion.viewpromo']}}
{{$productOrderCtrl.translations['antibody.pdp.commerceCard.promotion.promocode']}}: {{promo.promoCode}} {{promo.promoTitle}} {{promo.promoDescription}}. {{$productOrderCtrl.translations['antibody.pdp.commerceCard.promotion.learnmore']}}
产品信息
28513-1-AP
种属反应
宿主/亚型
分类
类型
抗原
偶联物
形式
浓度
规格
纯化类型
保存液
内含物
保存条件
运输条件
产品详细信息
Aliquoting is unnecessary for -20°C storage.
靶标信息
TYRO3 (tyrosine-protein kinase receptor TYRO3) is a receptor tyrosine kinase that transduces signals from the extracellular matrix into the cytoplasm by binding to several ligands including TULP1 or GAS6. It regulates many physiological processes including cell survival, migration, and differentiation. Ligand binding at the cell surface induces dimerization and autophosphorylation of TYRO3 on its intracellular domain that provides docking sites for downstream signaling molecules. Following activation by a ligand, TYRO3 plays a role in various processes such as neuron protection from excitotoxic injury, platelet aggregation, signal transduction, cell adhesion. and cytoskeleton reorganization.
仅用于科研。不用于诊断过程。未经明确授权不得转售。
生物信息学
蛋白别名: Bruton agammaglobulinemia tyrosine kinase; Etk2/tyro3; FLJ16467; soluble tyro 3; soluble tyro3; styro 3; styro3; TK19-2; tyro 3; TYRO3; TYRO3 protein tyrosine kinase 3; Tyrosine-protein kinase BYK; Tyrosine-protein kinase DTK; Tyrosine-protein kinase receptor TYRO3; Tyrosine-protein kinase RSE; Tyrosine-protein kinase SKY; Tyrosine-protein kinase TIF; unnamed protein product
基因别名: AI323366; Brt; BYK; DTK; Etk-2; etk2/tyro3; Rek; RSE; SKY; TIF; TK19-2; TYRO3
UniProt ID: (Human) Q06418, (Mouse) P55144, (Rat) P55146
Entrez Gene ID: (Human) 7301, (Mouse) 22174, (Rat) 25232